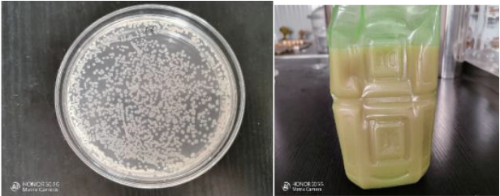

(一)成果简介
依托金年会体育环境微生物实验室平台和环境微生物方向的硕士、博士科研团队,开展废弃肉粉的二次资源开发。采用肉粉梯度、碳源梯度、生长因子梯度,结合pH、氧气、温度等环境因子,分别用单因素实验和正交实验优化配方,以肉粉处理量为主要考虑,以最终培养出的菌落数量作为配方选择依据;肉粉分解专用复合菌筛选,筛选出三种功能菌,可高效快速分解肉粉(24—72小时发酵结束),三种功能菌可进行复配,并且功能菌可以快速扩大繁殖,菌量可达到每毫升10亿级以上,可以研制成微生物菌剂、复合微生物肥料等产品,可用于农业种植,特别是经济作物、果蔬等作物种植,使用量大,具有良好的市场应用前景,能产生巨大的经济效益和社会效益。
技术优势:①复合功能菌发酵,可做复合微生物肥料;②发酵速度快,1-3天即可完成;③产生各种多肽、氨基酸等小分子有机营养,可满足作物生长需求。
技术创新点:①肉粉资源二次开发利用,大大提升附加值,安全高效;②复合菌高效分解肉粉,并培养成大量功能菌,降低用菌成本。
技术成熟度:可以量产
知识产权情况:其他
(二)应用情况
肉粉发酵液体有机菌肥成品,根据土壤湿度情况,稀释50-200倍,与其他营养元素(氮磷钾+中微量元素)复配,应用于赣南脐橙、沃柑种植、柚子和蔬菜等作物追肥浇灌。功能菌的作用明显,土壤疏松并形成团粒结构,土壤生态得到极大改善,可以保水保肥、减肥增效,果实品质和口感大幅度提升。
(三)市场化前景
肉粉液体有机菌肥成品,可以研制成微生物菌剂、复合微生物肥料等产品,用于农业种植,特别是经济作物、果蔬等作物种植,作物种类多,应用种植面积以百万亩计,市场容量大,具有很好的应用市场,可产生巨大的经济效益和社会效益。
//jyt.jiangxi.gov.cn/art/2024/11/18/art_84449_5062872.html